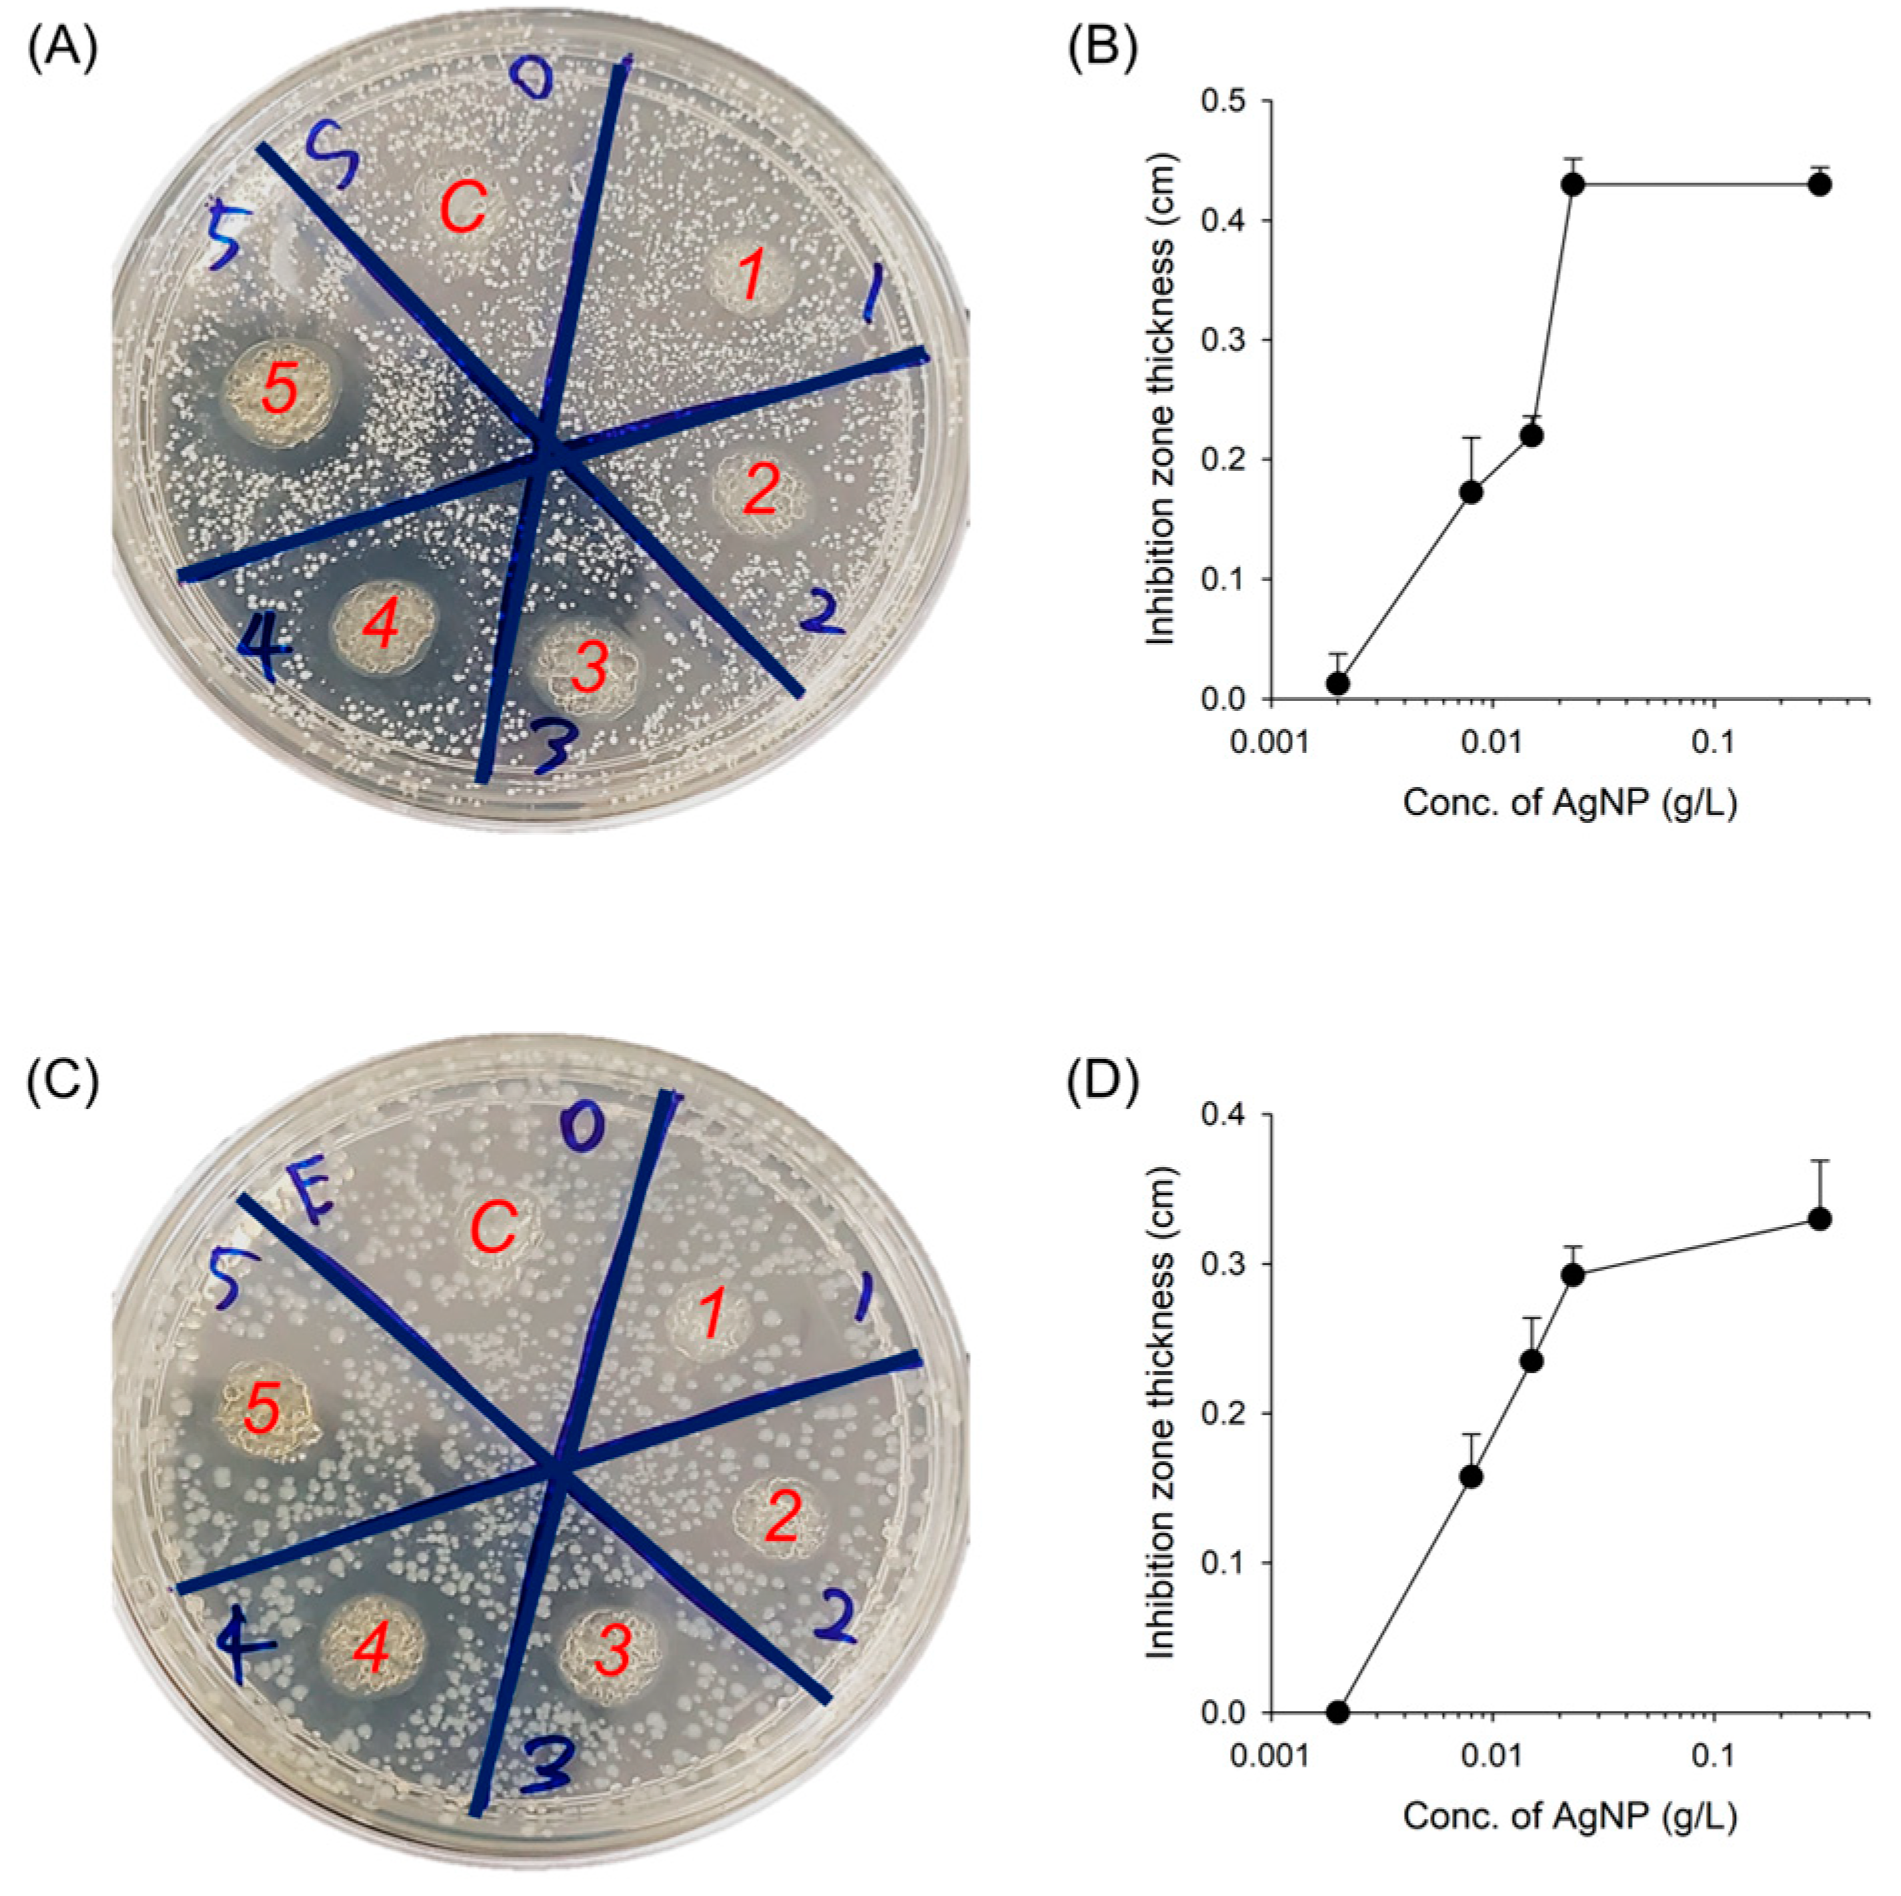

Silver-Composited Polydopamine Nanoparticles: Antibacterial and Antioxidant Potential in Nanocomposite Hydrogels
Abstract
1. Introduction
2. Results and Discussion
2.1. Preparation and Characterization of AgNPs
2.2. In Vitro Antibacterial Activity
2.3. In Vitro Antioxidant Activity
2.4. In Vitro Antibacterial Activity of AgNP-Incorporated Hydrogel Composites
2.5. Biocompatibility of AgNP-Incorporated Hydrogel Composites
3. Conclusions
4. Materials and Methods
4.1. Synthesis of AgNPs
4.2. Characterization of AgNPs
4.3. Antibacterial Activity of AgNPs
4.4. Antioxidant Activity of AgNPs
4.5. Preparation of Hydrogels
4.6. Cell Culture and Cell Viability
4.7. Statistical Analysis
Supplementary Materials
Author Contributions
Funding
Institutional Review Board Statement
Informed Consent Statement
Data Availability Statement
Conflicts of Interest
References
- Kim, S.; Lee, M. Rational design of hydrogels to enhance osteogenic potential. Chem. Mater. 2020, 32, 9508–9530. [Google Scholar] [CrossRef]
- Kharaziha, M.; Baidya, A.; Annabi, N. Rational design of immunomodulatory hydrogels for chronic wound healing. Adv. Mater. 2021, 33, 2100176. [Google Scholar] [CrossRef]
- Lee, C.-S.; Singh, R.K.; Hwang, H.S.; Lee, N.-H.; Kurian, A.G.; Lee, J.-H.; Kim, H.S.; Lee, M.; Kim, H.-W. Materials-based nanotherapeutics for injured and diseased bone. Prog. Mater. Sci. 2023, 135, 101087. [Google Scholar] [CrossRef]
- Skorokhoda, V.; Melnyk, Y.; Shalata, V.; Skorokhoda, T.; Suberliak, S. An investigation of obtaining patterns, structure and diffusion properties of biomedical purpose hydrogel membranes. East. Eur. J. Adv. Technol. 2017, 1, 50–55. [Google Scholar] [CrossRef]
- Elisseeff, J.; Puleo, C.; Yang, F.; Sharma, B. Advances in skeletal tissue engineering with hydrogels. Orthod. Craniofacial Res. 2005, 8, 150–161. [Google Scholar] [CrossRef]
- Kim, S.; Fan, J.; Lee, C.-S.; Lee, M. Dual functional lysozyme–chitosan conjugate for tunable degradation and antibacterial activity. ACS Appl. Bio Mater. 2020, 3, 2334–2343. [Google Scholar] [CrossRef]
- Zhao, X.; Wu, H.; Guo, B.; Dong, R.; Qiu, Y.; Ma, P.X. Antibacterial anti-oxidant electroactive injectable hydrogel as self-healing wound dressing with hemostasis and adhesiveness for cutaneous wound healing. Biomaterials 2017, 122, 34–47. [Google Scholar] [CrossRef]
- Lee, C.S.; Hwang, H.S.; Kim, S.; Fan, J.; Aghaloo, T.; Lee, M. Inspired by nature: Facile design of nanoclay–organic hydrogel bone sealant with multifunctional properties for robust bone regeneration. Adv. Funct. Mater. 2020, 30, 2003717. [Google Scholar] [CrossRef]
- Kannon, G.A.; Garrett, A.B. Moist wound healing with occlusive dressings: A clinical review. Dermatol. Surg. 1995, 21, 583–590. [Google Scholar] [CrossRef]
- Varaprasad, K.; Mohan, Y.M.; Ravindra, S.; Reddy, N.N.; Vimala, K.; Monika, K.; Sreedhar, B.; Raju, K.M. Hydrogel–silver nanoparticle composites: A new generation of antimicrobials. J. Appl. Polym. Sci. 2010, 115, 1199–1207. [Google Scholar] [CrossRef]
- Rai, M.; Yadav, A.; Gade, A. Silver nanoparticles as a new generation of antimicrobials. Biotechnol. Adv. 2009, 27, 76–83. [Google Scholar] [CrossRef] [PubMed]
- Jadhav, S.A.; Patil, A.H.; Thoravat, S.S.; Patil, V.S.; Patil, P.S. A brief overview of antimicrobial nanotextiles prepared by in situ synthesis and deposition of silver nanoparticles on cotton. Nanobiotechnology Rep. 2021, 16, 543–550. [Google Scholar] [CrossRef]
- Patil, A.H.; Jadhav, S.A.; More, V.B.; Sonawane, K.D.; Patil, P.S. Novel one step sonosynthesis and deposition technique to prepare silver nanoparticles coated cotton textile with antibacterial properties. Colloid J. 2019, 81, 720–727. [Google Scholar] [CrossRef]
- Patil, A.H.; Jadhav, S.A.; Gurav, K.D.; Waghmare, S.R.; Patil, G.D.; Jadhav, V.D.; Vhanbatte, S.H.; Kadole, P.V.; Sonawane, K.D.; Patil, P.S. Single step green process for the preparation of antimicrobial nanotextiles by wet chemical and sonochemical methods. J. Text. Inst. 2020, 111, 1380–1388. [Google Scholar] [CrossRef]
- Khan, Z.; Al-Thabaiti, S.A.; Obaid, A.Y.; Al-Youbi, A. Preparation and characterization of silver nanoparticles by chemical reduction method. Colloids Surf. B Biointerfaces 2011, 82, 513–517. [Google Scholar] [CrossRef] [PubMed]
- Srikar, S.K.; Giri, D.D.; Pal, D.B.; Mishra, P.K.; Upadhyay, S.N. Green synthesis of silver nanoparticles: A review. Green Sustain. Chem. 2016, 6, 34–56. [Google Scholar] [CrossRef]
- Chen, P.; Song, L.; Liu, Y.; Fang, Y.-E. Synthesis of silver nanoparticles by γ-ray irradiation in acetic water solution containing chitosan. Radiat. Phys. Chem. 2007, 76, 1165–1168. [Google Scholar] [CrossRef]
- Shevtsova, T.; Cavallaro, G.; Lazzara, G.; Milioto, S.; Donchak, V.; Harhay, K.; Korolko, S.; Budkowski, A.; Stetsyshyn, Y. Temperature-responsive hybrid nanomaterials based on modified halloysite nanotubes uploaded with silver nanoparticles. Colloids Surf. A Physicochem. Eng. Asp. 2022, 641, 128525. [Google Scholar] [CrossRef]
- Zhang, A.; Neumeyer, J.L.; Baldessarini, R.J. Recent progress in development of dopamine receptor subtype-selective agents: Potential therapeutics for neurological and psychiatric disorders. Chem. Rev. 2007, 107, 274–302. [Google Scholar] [CrossRef]
- Della Vecchia, N.F.; Avolio, R.; Alfè, M.; Errico, M.E.; Napolitano, A.; d'Ischia, M. Building-block diversity in polydopamine underpins a multifunctional eumelanin-type platform tunable through a quinone control point. Adv. Funct. Mater. 2013, 23, 1331–1340. [Google Scholar] [CrossRef]
- Kang, S.M.; You, I.; Cho, W.K.; Shon, H.K.; Lee, T.G.; Choi, I.S.; Karp, J.M.; Lee, H. One-step modification of superhydrophobic surfaces by a mussel-inspired polymer coating. Angew. Chem. Int. Ed. 2010, 49, 9401–9404. [Google Scholar] [CrossRef] [PubMed]
- Lee, C.-S.; Kim, S.; Fan, J.; Hwang, H.S.; Aghaloo, T.; Lee, M. Smoothened agonist sterosome immobilized hybrid scaffold for bone regeneration. Sci. Adv. 2020, 6, eaaz7822. [Google Scholar] [CrossRef] [PubMed]
- Lee, C.-S.; Hsu, G.C.-Y.; Sono, T.; Lee, M.; James, A.W. Development of a biomaterial scaffold integrated with osteoinductive oxysterol liposomes to enhance hedgehog signaling and bone repair. Mol. Pharm. 2021, 18, 1677–1689. [Google Scholar] [CrossRef] [PubMed]
- Hussain, M.; Suo, H.; Xie, Y.; Wang, K.; Wang, H.; Hou, Z.; Gao, Y.; Zhang, L.; Tao, J.; Jiang, H. Dopamine-substituted multidomain peptide hydrogel with inherent antimicrobial activity and antioxidant capability for infected wound healing. ACS Appl. Mater. Interfaces 2021, 13, 29380–29391. [Google Scholar] [CrossRef]
- Li, Y.; Wen, J.; Qin, M.; Cao, Y.; Ma, H.; Wang, W. Single-molecule mechanics of catechol-iron coordination bonds. ACS Biomater. Sci. Eng. 2017, 3, 979–989. [Google Scholar] [CrossRef]
- Petrus, E.; Tinakumari, S.; Chai, L.; Ubong, A.; Tunung, R.; Elexson, N.; Chai, L.; Son, R. A study on the minimum inhibitory concentration and minimum bactericidal concentration of Nano Colloidal Silver on food-borne pathogens. Int. Food Res. J. 2011, 18, 55–66. [Google Scholar]
- Parvekar, P.; Palaskar, J.; Metgud, S.; Maria, R.; Dutta, S. The minimum inhibitory concentration (MIC) and minimum bactericidal concentration (MBC) of silver nanoparticles against Staphylococcus aureus. Biomater. Investig. Dent. 2020, 7, 105–109. [Google Scholar] [CrossRef]
- Liang, Y.; Zhao, X.; Hu, T.; Han, Y.; Guo, B. Mussel-inspired, antibacterial, conductive, antioxidant, injectable composite hydrogel wound dressing to promote the regeneration of infected skin. J. Colloid Interface Sci. 2019, 556, 514–528. [Google Scholar] [CrossRef]
- Jodko-Piórecka, K.; Litwinienko, G. Antioxidant activity of dopamine and L-DOPA in lipid micelles and their cooperation with an analogue of α-tocopherol. Free Radic. Biol. Med. 2015, 83, 1–11. [Google Scholar] [CrossRef]
- Divband, B.; Aghazadeh, M.; Al-Qaim, Z.H.; Samiei, M.; Hussein, F.H.; Shaabani, A.; Shahi, S.; Sedghi, R. Bioactive chitosan biguanidine-based injectable hydrogels as a novel BMP-2 and VEGF carrier for osteogenesis of dental pulp stem cells. Carbohydr. Polym. 2021, 273, 118589. [Google Scholar] [CrossRef]
- Sun, M.; Sun, X.; Wang, Z.; Guo, S.; Yu, G.; Yang, H. Synthesis and properties of gelatin methacryloyl (GelMA) hydrogels and their recent applications in load-bearing tissue. Polymers 2018, 10, 1290. [Google Scholar] [CrossRef]
- Cui, Z.-K.; Kim, S.; Baljon, J.J.; Wu, B.M.; Aghaloo, T.; Lee, M. Microporous methacrylated glycol chitosan-montmorillonite nanocomposite hydrogel for bone tissue engineering. Nat. Commun. 2019, 10, 3523. [Google Scholar] [CrossRef]
- Chen, C.; Rehnama, M.; Kim, S.; Lee, C.S.; Zhang, X.; Aghaloo, T.; Fan, J.; Lee, M. Enhanced Osteoinductivity of Demineralized Bone Matrix with Noggin Suppression in Polymer Matrix. Adv. Biol. 2021, 5, 2000135. [Google Scholar] [CrossRef] [PubMed]
- Khorrami, S.; Zarrabi, A.; Khaleghi, M.; Danaei, M.; Mozafari, M. Selective cytotoxicity of green synthesized silver nanoparticles against the MCF-7 tumor cell line and their enhanced antioxidant and antimicrobial properties. Int. J. Nanomed. 2018, 13, 8013. [Google Scholar] [CrossRef]
- Ahmadian, E.; Dizaj, S.M.; Rahimpour, E.; Hasanzadeh, A.; Eftekhari, A.; Halajzadeh, J.; Ahmadian, H. Effect of silver nanoparticles in the induction of apoptosis on human hepatocellular carcinoma (HepG2) cell line. Mater. Sci. Eng.: C 2018, 93, 465–471. [Google Scholar] [CrossRef]
- Van Den Bulcke, A.I.; Bogdanov, B.; De Rooze, N.; Schacht, E.H.; Cornelissen, M.; Berghmans, H. Structural and rheological properties of methacrylamide modified gelatin hydrogels. Biomacromolecules 2000, 1, 31–38. [Google Scholar] [CrossRef]
- Hu, J.; Hou, Y.; Park, H.; Choi, B.; Hou, S.; Chung, A.; Lee, M. Visible light crosslinkable chitosan hydrogels for tissue engineering. Acta Biomater. 2012, 8, 1730–1738. [Google Scholar] [CrossRef]
- Amsden, B.G.; Sukarto, A.; Knight, D.K.; Shapka, S.N. Methacrylated glycol chitosan as a photopolymerizable biomaterial. Biomacromolecules 2007, 8, 3758–3766. [Google Scholar] [CrossRef]
- Kim, S.; Fan, J.; Lee, C.-S.; Chen, C.; Bubukina, K.; Lee, M. Heparinized chitosan stabilizes the bioactivity of BMP-2 and potentiates the osteogenic efficacy of demineralized bone matrix. J. Biol. Eng. 2020, 14, 6. [Google Scholar] [CrossRef]
- Fan, J.; Lee, C.-S.; Kim, S.; Chen, C.; Aghaloo, T.; Lee, M. Generation of small RNA-modulated exosome mimetics for bone regeneration. ACS Nano 2020, 14, 11973–11984. [Google Scholar] [CrossRef]

Disclaimer/Publisher’s Note: The statements, opinions and data contained in all publications are solely those of the individual author(s) and contributor(s) and not of MDPI and/or the editor(s). MDPI and/or the editor(s) disclaim responsibility for any injury to people or property resulting from any ideas, methods, instructions or products referred to in the content. |
© 2023 by the authors. Licensee MDPI, Basel, Switzerland. This article is an open access article distributed under the terms and conditions of the Creative Commons Attribution (CC BY) license (https://creativecommons.org/licenses/by/4.0/).
Share and Cite
Song, G.-J.; Choi, Y.-S.; Hwang, H.-S.; Lee, C.-S. Silver-Composited Polydopamine Nanoparticles: Antibacterial and Antioxidant Potential in Nanocomposite Hydrogels. Gels 2023, 9, 183. https://doi.org/10.3390/gels9030183
Song G-J, Choi Y-S, Hwang H-S, Lee C-S. Silver-Composited Polydopamine Nanoparticles: Antibacterial and Antioxidant Potential in Nanocomposite Hydrogels. Gels. 2023; 9(3):183. https://doi.org/10.3390/gels9030183
Chicago/Turabian StyleSong, Geun-Jin, Yeon-Su Choi, Hee-Sook Hwang, and Chung-Sung Lee. 2023. "Silver-Composited Polydopamine Nanoparticles: Antibacterial and Antioxidant Potential in Nanocomposite Hydrogels" Gels 9, no. 3: 183. https://doi.org/10.3390/gels9030183
APA StyleSong, G.-J., Choi, Y.-S., Hwang, H.-S., & Lee, C.-S. (2023). Silver-Composited Polydopamine Nanoparticles: Antibacterial and Antioxidant Potential in Nanocomposite Hydrogels. Gels, 9(3), 183. https://doi.org/10.3390/gels9030183
